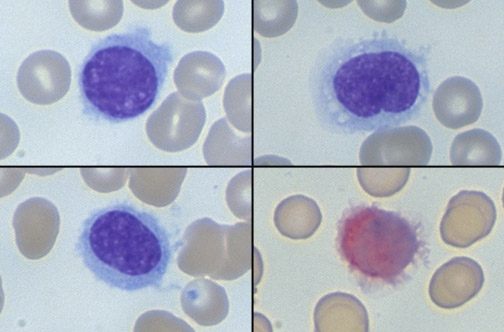

![]() | This collage of cells on peripheral blood smears depicts abnormal lymphocytes with indistinct cytoplasmic borders and projections, giving the cells a "hairy" appearance. At the lower right can be seen one of these cells with red cytoplasmic staining indicative of tartrate resistant acid phosphatase (TRAP) positivity. This is hairy cell leukemia, an uncommon B cell proliferation seen mostly in older males and marked by marrow involvement, pancytopenia, and splenomegaly. |
![]() |